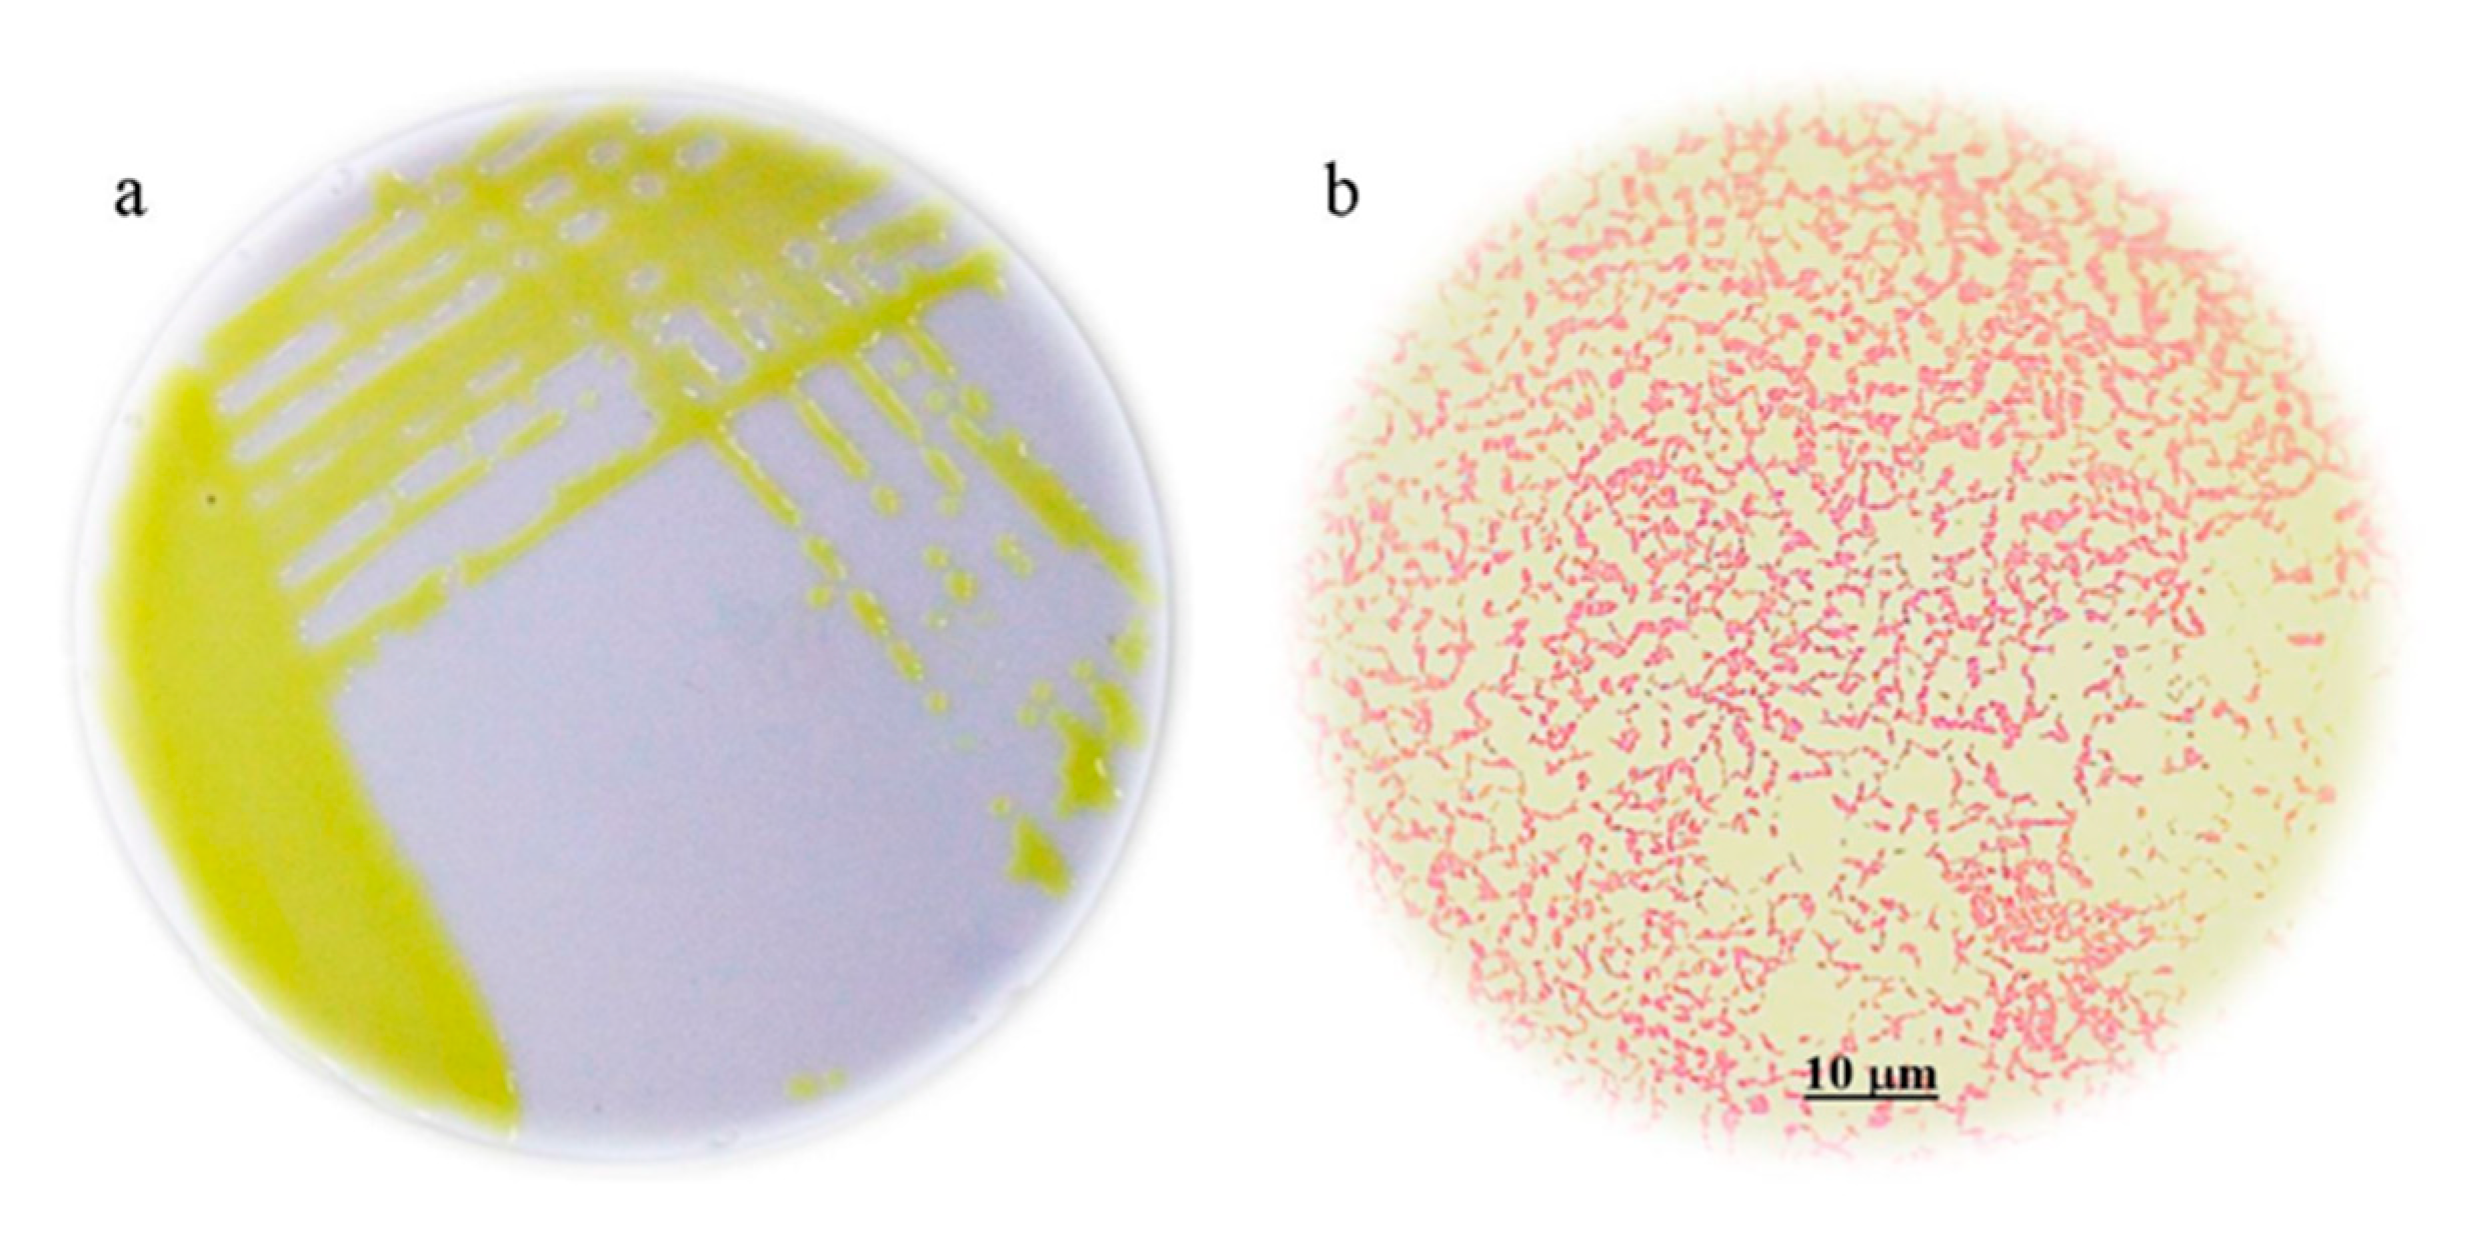
Applsci 11 05391 g001 Applsci 11 05391 g001
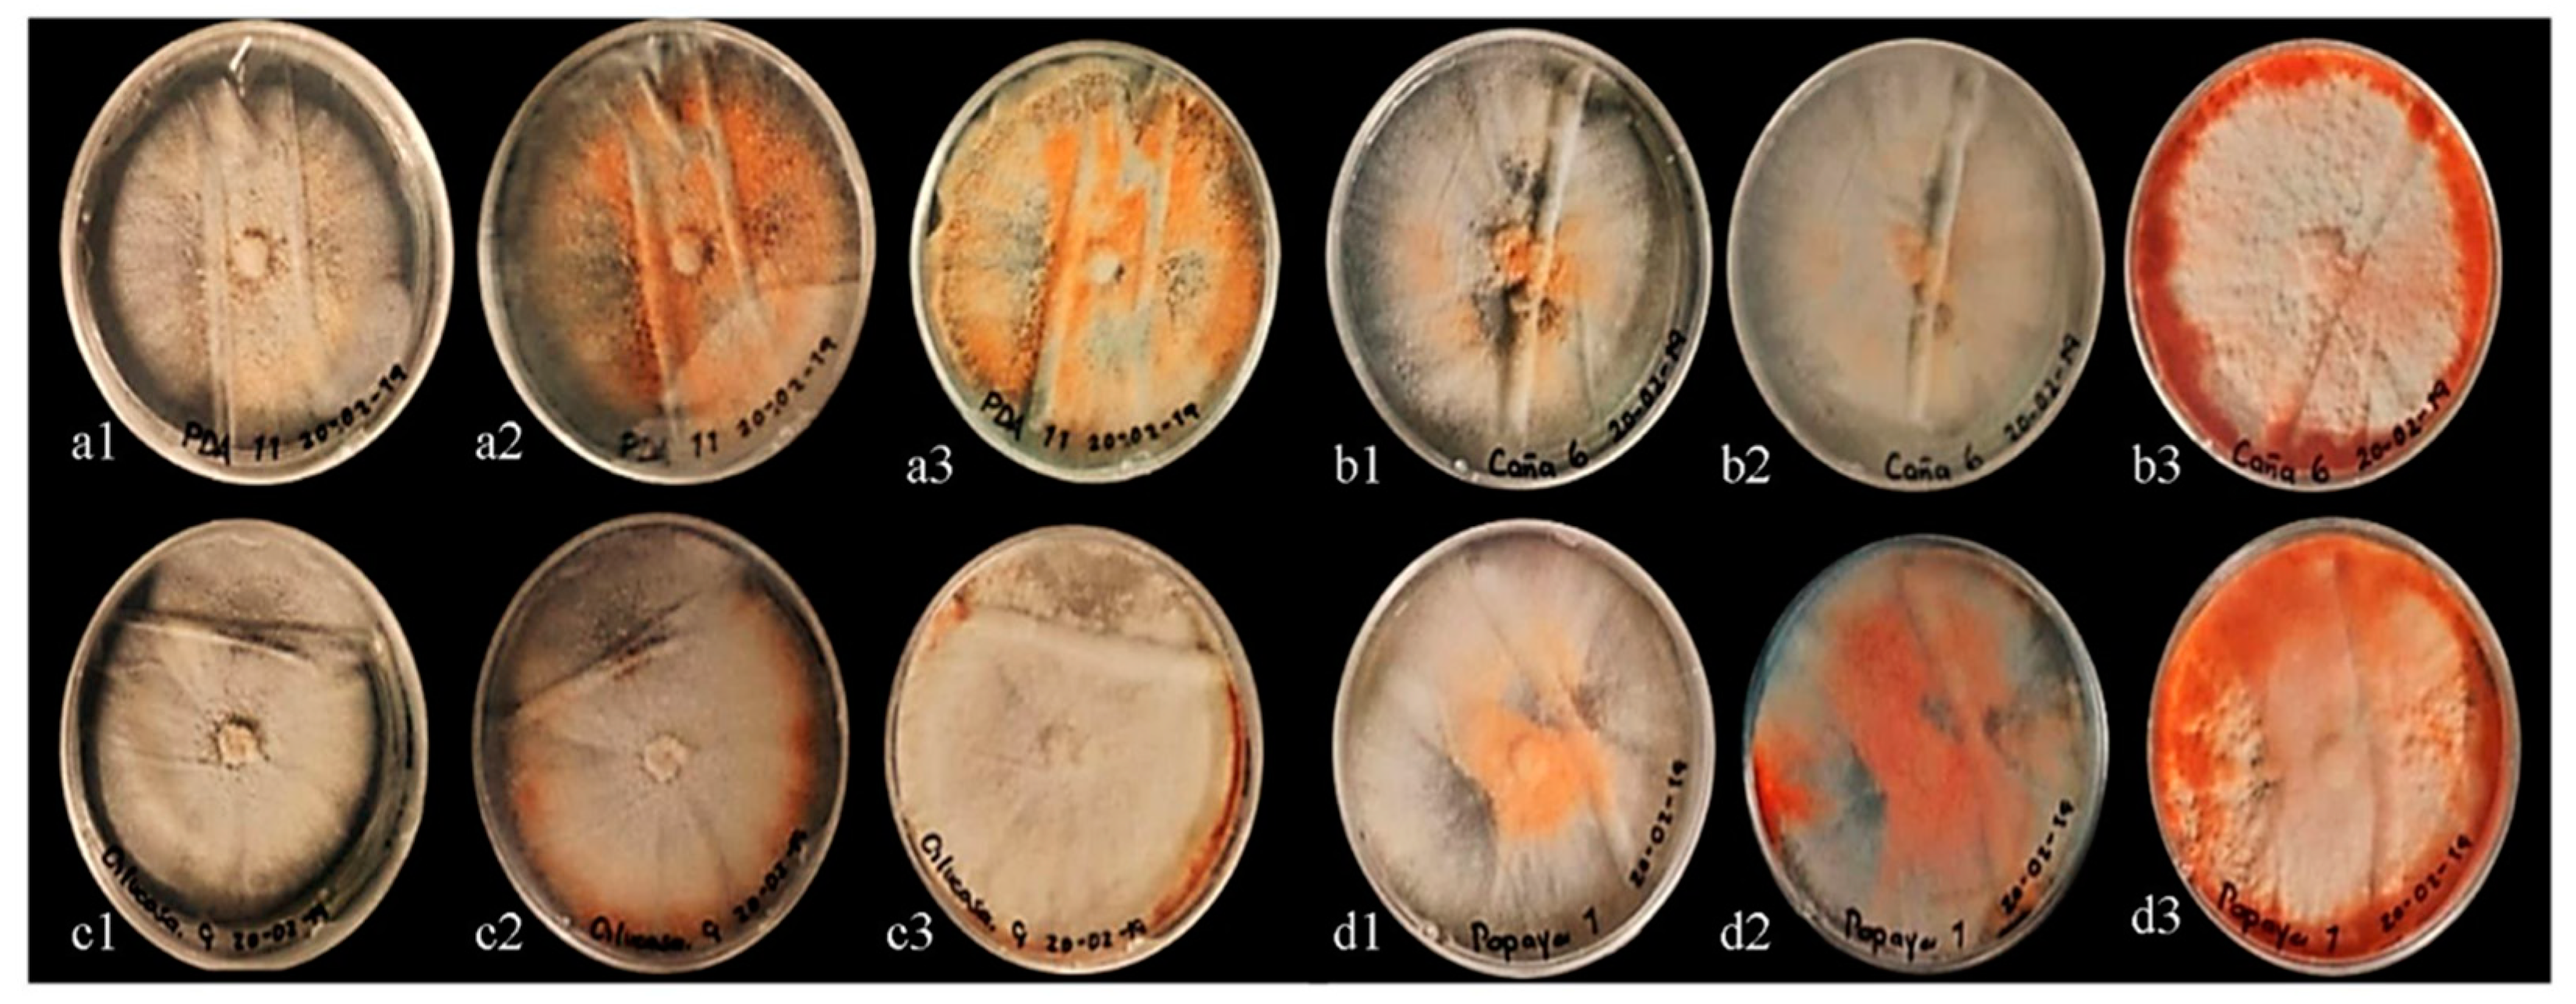
Applsci 11 05391 g003 Applsci 11 05391 g003

In Vitro Antimicrobial Activity of Cinnabarin on Xanthomonas campestris Isolated from Bean Crops of Puebla, Mexico
Abstract
1. Introduction
2. Materials and Methods
2.1. Isolation of Causal Agent of Bacterial Blight
2.2. Molecular Identification
2.3. In Vitro Pathogenicity Tests
2.4. Production and Synthesis of Cinnabarin from Pycnoporus sanguineus
2.5. Purification of Cinnabarin
2.6. Antimicrobial Activity
2.7. Statistical Analysis
3. Results
3.1. Isolation, Characterization and Identification of the Causative Agent of Bacterial Blight
3.2. Pathogenicity Tests
3.3. Evaluation of Synthesis of Cinnabarin from Pycnoporus sanguineus
3.4. Antimicrobial Activity In Vitro
4. Discussion
5. Conclusions
Supplementary Materials
Author Contributions
Funding
Institutional Review Board Statement
Informed Consent Statement
Data Availability Statement
Acknowledgments
Conflicts of Interest
References
- Nassary, E.K.; Baijukya, F.; Ndakidemi, P.A. Assessing the Productivity of Common Bean in Intercrop with Maize across Agro-Ecological Zones of Smallholder Farms in the Northern Highlands of Tanzania. Agriculture 2020, 10, 117. [Google Scholar] [CrossRef]
- Food and Agriculture Organization (FAO). Agriculture Production and Trade Statistics; Food and Agriculture Organization of the United Nations: Rome, Italy, 2021; Available online: http://www.fao.org/faostat/en/ (accessed on 28 May 2021).
- SIAP-SAGARPA. Servicio de Información Agroalimentaria y Pesquera. Secretaria de Agricultura, Ganadería, Desarrollo Rural, Pesca y Alimentación. 2021. Available online: www.siap.gob.mx (accessed on 30 May 2021).
- Tugume, J.K.; Osundwa, C.; Tusiime, G.; Mukankusi, C.M.; Ssekamate, A.M.; Wasswa, P.; Buruchar, R. Pathogenicity and virulence of Uganda isolates of common bacterial blight disease pathogen (Xanthomonas spp.). Afr. Crop Sci. J. 2020, 28, 213–226. [Google Scholar] [CrossRef]
- Corzo, M.; Quiñones, M.; Martinez-Coca, B.; Rivero, D.; Zamora-Gutierrez, L.; Martinez-Zubiaur, Y.; Plasencia-Marquez, O.; Pauls, K.P. Current situation of Xanthomonas spp., and Phaseolus vulgaris L. pathosystem in the west region of Cuba. Phytopathology 2019, 109. [Google Scholar] [CrossRef]
- Francisco, F.N.; Gallegos, M.G.; Ochoa, F.Y.; Hernández, C.F.; Benavides, M.A.; Castillo, R.F. Aspectos fundamentales del tizon común bacteriano (Xanthomonas axonopodis pv. phaseoli Smith): Características, patogenicidad y control. Revista Mexicana de Fitopatología 2013, 31, 147–160. [Google Scholar]
- Aguilar, C.; Mano, M.; Eulalio, A. Micro-RNAs at the host-bacteria interface: Host defense or bacterial offense. Trends Microbiol. 2019, 27, 206–218. [Google Scholar] [CrossRef] [PubMed]
- Zavaleta, M.E. Alternativas de manejo de las enfermedades de las plantas. Terra Latinoamericana 1999, 17, 201–207. [Google Scholar]
- Rossbacher, S.; Vorburger, C. Prior adaptation of parasitoids improves biological control of symbiont-protected pests. Ecol. Appl. 2020, 13, 1868–1876. [Google Scholar] [CrossRef]
- Cruz, M.R.; Piña-Guzmán, A.B.; Yáñez-Fernández, J.; Valencia, D.G.; Bautista-Baños, S.; Villanueva, A.R. Producción de pigmentos de Pycnoporus sanguineus en medio de cultivo sólido. Agrociencia 2015, 49, 347–359. [Google Scholar]
- Zhang, Y.; Cao, J.; Wang, J.; Cheng, Y.; Zhou, M.; Wang, W.; Geng, M.; Xu, D.; Xu, Z. Comparative genomicsuncovers genetic diversity and synthetic biology of secondary metabolite production of the genus Trametes. Res. Sq. 2019, 1–25. [Google Scholar] [CrossRef]
- Téllez-Téllez, M.; Villegas, E.; Rodríguez, A.; Acosta-Urdapilleta, M.L.; O’Donovan, A.; Díaz-Godínez, G. Mycosphere Essay Fungi of Pycnoporus: Morphological and molecular identification, worldwide distribution and biotechnological potential. Mycosphere 2016, 7, 1500–1525. [Google Scholar] [CrossRef]
- García, E. Modificaciones al Sistema de Clasificación Climática de Köppen; Instituto de Geografía, Universidad Autónoma de México: Mexico City, Mexico, 2004; 170p. [Google Scholar]
- Escalona, Y.; Sanabria, M.; Rodriguez, D.; Ricón, N. Prevalencia de patógenos bacterianos en cultivos hortícolas a cielo abierto del municipio Jiménez, Estado Lara y evaluación de control alternativo mediante uso de extracto etanólico de Lippia origanoides. Revista de la Universidad de Zulia 2019, 10, 58–81. [Google Scholar]
- Rashidah, R.A.; Hasan, N.; Ramachandran, K. Screening of endophytic bacteria as biocontrol agents against bacteria leaf blight (Xanthomonas oryzae). Hayati J. Biosci. 2020, 27, 215–220. [Google Scholar]
- Popovic, T.; Balaz, J.; Ignjatov, M.; Mitrovic, P.; Gavrilovic, V.; Josic, D. Identification and Genetic Characterisation of Xanthomonas campestris pv. campestris as an Oilseed rape Pathogen in Serbia. J. Plant Pathol. 2014, 96, 553–560. [Google Scholar]
- Nico, A.I.; Alippi, A.M.; Dal-Bo, E.; Ronco, L.B. Interacción de Pseudomonas corrugata y Pseudomonas viridiflava y diferentes genotipos de tomate. Revista de la Facultad de Agronomía 2006, 6, 37–45. [Google Scholar] [CrossRef]
- Zeravakis, G.; Philippoussis, A.; Ioannidou, S.; Diamantopoulou, P. Mycelium growth kinetics and optimal temperature conditions for the cultivation of edible mushroom species on lignocellulosic substrates. Folia Microbiológica 2001, 46, e231. [Google Scholar] [CrossRef] [PubMed]
- Muy-Rangel, M.D.; Osuna-Valle, J.R.; García-Estrada, R.S.; Martín-Hernández, C.; Quintana-Obregón, E.A. Actividad antifúngica in vitro del aceite esencial de ajo (Allium sativum L.) contra Alternaria tenuissima. Revista Mexicana de Fitopatología 2018, 36, 162–171. [Google Scholar] [CrossRef]
- Smânia, E.F.; Smaünia, A.; Loguercio-Leite, C. Optimal parameters for cinnabarin synthesis by Pycnoporus sanguineus. J. Chem. Technol. Biotechnol. 1997, 70, 57–59. [Google Scholar] [CrossRef]
- Smânia, J.A.; Dellemonache, F.; Smânia, E.F.A.; Gil, M.L.; Benchetrit, L.C.; Cruz, F.S. Antibacterial activity of a substance produced by the fungus, Pycnoporus sanguineus (Fr.). Murr. J. Ethnopharmacol. 1995, 45, 177–181. [Google Scholar] [CrossRef]
- Smânia, E.F.A.; Smânia, J.A.; Loguercio-Leite, C. Cinnabarin synthesis by Pycnoporus sanguineus strains and antimicrobial activity against bacteria from food products. Revista de Microbiologia 1998, 29, 317–320. [Google Scholar] [CrossRef]
- Moulari, B.; Pellequer, Y.; Lboutounne, H.; Girad, C.; Chaumont, J.; Millet, J.; Muyar, F. Isolation and in vitro antibacterial activity of astilbin, the bioactive flavonone from the leaves of Harungana madagascariensis Lam. ex Poir. (Hypericaceae). Ethnopharmacology 2006, 106, 272–278. [Google Scholar] [CrossRef]
- Norma Oficial Mexicana (NOM-181-SSA1). Salud Ambiental. Agua para uso y Consumo Humano. Requisitos Sanitarios que Deben Cumplir las Sustancias Germicidas para Tratamiento de Agua, de Tipo Doméstico. 1998. Available online: http://legismex.mty.itesm.mx/normas/ssa1/ssa1181.pdf (accessed on 2 April 2021).
- Moreno-Limón, S.; González-Solís, L.N.; Salcedo-Martínez, S.M.; Cárdenas-Avila, M.L.; Perales-Ramírez, A. Efecto antifúngico de extractos de gobernadora (Larrea tridentata L.) sobre la inhibición in vitro de Aspergillus flavus y Penicillium sp. Polibotánica 2011, 32, 193–205. [Google Scholar]
- Cormican, M.G.; Pfaller, M.A. Standardization of antifungal susceptibility testing. J. Antimicrob. Chemother. 1996, 38, 561–578. [Google Scholar] [CrossRef] [PubMed][Green Version]
- Schaad, N.W.; Jones, J.B.; Chun, W. Laboratory Guide for Identification of Plant Pathogenic Bacteria. Biologia Plantarum 2001, 44, e546. [Google Scholar] [CrossRef]
- Lia, R.S.; Ali, M.R.; Jahan, M.S.; Akter, A.; Sumi, M.S.E.; Hasan, M.F.; Acharjee, U.K.; Islam, M.A.; Sikdar, B. Detection of Xanthomonas campestris pv. cucurbitae from bacterial leaf spot disease of cucumber and evaluation of its biological control. Adv. Biores. 2018, 9, 41–46. [Google Scholar] [CrossRef]
- Takeuchi, K.; Mitsuharaa, I. Complete Genome Sequences of Two Strains of Xanthomonas campestris pv. campestris Isolated in Japan Kasumi. Microbiol. Resour. Announc. 2020, 9, e01239-19. [Google Scholar] [CrossRef]
- Nei, M.; Kumar, S. Molecular and Evolution Phylogenetics; Oxford Univerity Press, Inc.: Oxford, UK, 2000; 333p. [Google Scholar]
- Botero, M.J.; Ramírez, M.C.; Castaño-Zapata, J. Determinación del periodo de incubación de Xanthomonas campestris pv. passiflorae, agente causante de la bacteriosis del maracuyá (Passiflora edulis var. flavicarpa Degener). Boletín Fitotecnia 2006, 107, 1–5. [Google Scholar]
- Pinto, F.; Oliveira, F.; Cardoso, J.; Vidal, J. Principais doenças do maracujazeiro na região nordeste e seu controle. Comunicado Técnico 2003, 86, 1–12. [Google Scholar]
- Popović, T.; Mitrović, P.; Jelušić, A.; Dimkić, I.; Marjanović-Jeromela, A.; Nikolić, I.; Stanković, S. Genetic diversity and virulence of Xanthomonas campestris pv. campestris isolates from Brassica napus and six Brassica oleracea crops in Serbia. Plant Pathol. 2019, 68, 1448–1457. [Google Scholar] [CrossRef]
- Baumer, J.D.; Mas-Diego, S.; Pacheco, S.M.V.; Morgado, A.F.M.; Furigo, A.F. Comparative study of mycelial growth and production of cinnabarin by different strains of Pycnoporus sanguineus. Biofar Rev. Biol. Farm. 2008, 2, 1–5. [Google Scholar]
- Papinutti, L. Pycnoporus sanguineus. Fichas Micológicas. Revista Boletín Biológica 2013, 7, 31–32. [Google Scholar]
- Acosta, L.; Medardo, F.; Villegas, A. Cultivo de Pycnoporus sanguineus en aserrín de pino, encino y cedro. In Hongos Comestibles y Medicinales en Iberoamérica: Investigación y Desarrollo en un Entorno Multicultural; Sánchez, J., Mata, G., Eds.; Instituto de Ecología: Tapachula, Mexico, 2013; pp. 329–338. ISBN 978-607-7637-73-8. [Google Scholar]
- Rosales-Lopez, C. Other important use of mushrooms. Tecnol Marcha 2019, 32, 82–90. [Google Scholar] [CrossRef]
- Cruz-Muñoz, R. Producción de Extractos de Pycnoporus sanguineus con Actividad Antimicrobiana en Hongos y Bacterias Fitopatógenas. Tesis de Maestría, Instituto Politécnico Nacional, Mexico City, Mexico, 2012; 109p. Available online: http://repositoriodigital.ipn.mx/handle/123456789/15754 (accessed on 14 October 2020).
- Keller, N.P.; Turner, G.; Bennett, J.W. Fungal secondary metabolism-from biochemistry to genomics. Nat. Rev. Microbiol. 2005, 3, 937–947. [Google Scholar] [CrossRef] [PubMed]
- Hwang, H.J.; Kim, S.W.; Xu, C.P.; Choi, J.W.; Yun, J.W. Morphological and rheological properties of the three different species of basidiomycetes Phellinus in submerged cultures. Appl. Microbiol. Biotechnol. 2004, 96, 1296–1305. [Google Scholar] [CrossRef] [PubMed]
- Toillier, S.L.; Iurkiv, L.; Meinerz, C.C.; Baldo, M.; Viecelli, C.A.; Kuhn, O.J.; Schwan-Estrada, K.R.F.; Stangarlin, J.R. Controle de crestamento bacteriano común (Xanthomonas axonopodis pv. phaseoli) e alteracoes bioquímicas em feijoeiro induzidas por Pycnoporus sanguineu. Arq. Inst. Biol. 2010, 77, 99–110. [Google Scholar] [CrossRef]
- Bose, S.R. Antibiotics in a Polyporus (Polystictus sanguineus). Nature 1946, 158, 292–296. [Google Scholar] [CrossRef] [PubMed]
- Rosa, L.H.; Machado, K.M.G.; Jacob, C.C.; Capelari, M.; Rosa, C.A.; Zani, C.L. Screening of Brazilian basidiomycetes for antimicrobial activity. Memórias do Instituto Oswaldo Cruz 2003, 98, 967–974. [Google Scholar] [CrossRef]
- Sanchez-Perez, J.A.; Béjar-Castillo, V.; Villanueva-Cotrina, F.; Guevara-Granados, J.M. Actividad antimicrobiana de metabolitos secundarios de Aspergillus fumigatus sensu stricto sobre cepas clínicas de Staphylococcus aureus y Streptococcus pneumoniae. Anales de la Facultad de Medicina 2020, 81, 180–185. [Google Scholar] [CrossRef]
- León, S.I. La antracnosis y la mancha angular del frijol común (Phaseolus vulgaris L.). Temas de Ciencia y Tecnología 2009, 45–59. Available online: https://www.utm.mx/edi_anteriores/Temas39/2NOTAS%2039-3.pdf (accessed on 14 December 2020).
- Acosta-Urdapilleta, L.; Paz, G.A.; Rodríguez, A.; Adame, M.; Salgado, D.; Salgado, J.; Montiel-Peña, M.; Medrano-Vega, F.; Villegas-Villarrea, E.C. Pycnoporus sanguineus, un hongo con potencial biotecnológico. In Hacia un Desarrollo Sostenible del Sistema de Producción Consumo de los Hongos Comestibles y Medicinales en Latinoamérica: Avances y Perspectivas en el Siglo XXI; Martínez-Carrera, D., Curvetto, N., Sobal, M., Morales, P., Mora, V.-M., Eds.; Red Latinoamericana de Hongos Comestibles y Medicinales-COLPOS-UNS-CONACYT-AMC-UAEM-UPAEP-IMINAP: Puebla, México, 2010; 648p. [Google Scholar]

| Strain | Treatment | Growth (mm) * | Growth Speed (cm d−1) * | Biomass (mg box−1) * |
|---|---|---|---|---|
| P. sanguineus | PDA (Control) | 60.90 ± 0.82 d | 0.3625 ± 1.20 d | 44.12 ± 7.5 d |
| PDA+C | 78.41 ± 1.45 a | 0.4666 ± 1.33 a | 54.60 ± 10.2 a | |
| PDA+P | 72.85 ± 0.75 b | 0.4333 ± 0.43 b | 49.45 ± 11.9 c | |
| PDA+G | 68.67 ± 1.25 c | 0.4083 ± 1.52 b | 51.72 ± 8.6 b |
| Strain | Treatment | (Days) | Biomass Dissolved (g) * | Efficiency of the Extract (%) * | Inhibition Area (mm) * |
|---|---|---|---|---|---|
| CP-MaP (P. sanguineus) | PDA (Control) | 7 d | 0.001080 ± 0.07 g e | 2.45 ± 0.15% d | 8.13 ± 0.11 mm i |
| 14 d | 0.001654 ± 0.01 g e | 3.03 ± 0.19% d | 9.51 ± 1.04 mm ghi | ||
| 21 d | 0.001357 ± 0.09 g e | 2.74 ± 0.17% d | 11.14 ± 1.02 mm fg | ||
| PDA+P | 7 d | 0.001484 ± 0.01 g e | 2.87 ± 0.18% d | 11.74 ± 0.22 mm ef | |
| 14 d | 0.005344 ± 0.03 g d | 5.44 ± 0.35% c | 13.33 ± 2.68 mm de | ||
| 21 d | 0.009181 ± 0.06b g c | 7.13 ± 0.46% abc | 15.62 ± 0.91 mm bc | ||
| PDA+C | 7 d | 0.006735 ± 0.04 g cd | 6.11 ± 0.39% bc | 13.03 ± 1.28 mm de | |
| 14 d | 0.007481 ± 0.05 g cd | 6.44 ± 0.41% bc | 14.31 ± 0.38 mm cd | ||
| 21 d | 0.007493 ± 0.05 g cd | 6.44 ± 0.41% bc | 16.58 ± 1.26 mm b | ||
| PDA+G | 7 d | 0.013179 ± 0.00 g a | 8.54 ± 0.55% a | 9.16 ± 1.38 mm h | |
| 14 d | 0.008639 ± 0.06b g c | 6.92 ± 0.45% abc | 10.24 ± 0.15 mm fghi | ||
| 21 d | 0.010635 ± 0.07 g b | 7.68 ± 0.49% ab | 11.02 ± 1.72 mm fg | ||
| Control (−) | 7 d | - | - | 0.00 mm j | |
| 14 d | |||||
| 21 d | |||||
| Control (+) | 7 d | - | - | 25.02 ± 0.91mm a | |
| 14 d | |||||
| 21 d |
Publisher’s Note: MDPI stays neutral with regard to jurisdictional claims in published maps and institutional affiliations. |
© 2021 by the authors. Licensee MDPI, Basel, Switzerland. This article is an open access article distributed under the terms and conditions of the Creative Commons Attribution (CC BY) license (https://creativecommons.org/licenses/by/4.0/).
Share and Cite
Romero-Arenas, O.; Jara y Rivera, A.P.; Valencia de Ita, M.A.; Lezama, C.P.; Villa-Ruano, N.; Rivera, A. In Vitro Antimicrobial Activity of Cinnabarin on Xanthomonas campestris Isolated from Bean Crops of Puebla, Mexico. Appl. Sci. 2021, 11, 5391. https://doi.org/10.3390/app11125391
Romero-Arenas O, Jara y Rivera AP, Valencia de Ita MA, Lezama CP, Villa-Ruano N, Rivera A. In Vitro Antimicrobial Activity of Cinnabarin on Xanthomonas campestris Isolated from Bean Crops of Puebla, Mexico. Applied Sciences. 2021; 11(12):5391. https://doi.org/10.3390/app11125391
Chicago/Turabian StyleRomero-Arenas, Omar, Ana P. Jara y Rivera, Ma. Angeles Valencia de Ita, Conrado Parraguirre Lezama, Nemesio Villa-Ruano, and Antonio Rivera. 2021. "In Vitro Antimicrobial Activity of Cinnabarin on Xanthomonas campestris Isolated from Bean Crops of Puebla, Mexico" Applied Sciences 11, no. 12: 5391. https://doi.org/10.3390/app11125391
APA StyleRomero-Arenas, O., Jara y Rivera, A. P., Valencia de Ita, M. A., Lezama, C. P., Villa-Ruano, N., & Rivera, A. (2021). In Vitro Antimicrobial Activity of Cinnabarin on Xanthomonas campestris Isolated from Bean Crops of Puebla, Mexico. Applied Sciences, 11(12), 5391. https://doi.org/10.3390/app11125391







